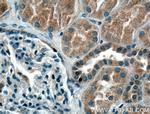
SIRT2 Antibody in Immunohistochemistry (Paraffin) (IHC (P))

Search
Proteintech
SIRT2 Monoclonal Antibody (1D8G10)
{{$productOrderCtrl.translations['antibody.pdp.commerceCard.promotion.promotions']}}
{{$productOrderCtrl.translations['antibody.pdp.commerceCard.promotion.viewpromo']}}
{{$productOrderCtrl.translations['antibody.pdp.commerceCard.promotion.promocode']}}: {{promo.promoCode}} {{promo.promoTitle}} {{promo.promoDescription}}. {{$productOrderCtrl.translations['antibody.pdp.commerceCard.promotion.learnmore']}}
产品信息
66410-1-IG
种属反应
宿主/亚型
分类
类型
克隆号
抗原
偶联物
形式
浓度
规格
纯化类型
保存液
内含物
保存条件
运输条件
产品详细信息
Immunogen sequence: MDFLRNLFS QTLSLGSQKE RLLDELTLEG VARYMQSERC RRVICLVGAG ISTSAGIPDF RSPSTGLYDN LEKYHLPYPE AIFEISYFKK HPEPFFALAK ELYPGQFKPT ICHYFMRLLK DKGLLLRCYT QNIDTLERIA GLEQEDLVEA HGTFYTSHCV SASCRHEYPL SWMKEKIFSE VTPKCEDCQS LVKPDIVFFG ESLPARFFSC MQSDFLKVDL LLVMGTSLQV QPFASLISKA PLSTPRLLIN KEKAGQSDPF LGMIMGLGGG MDFDSKKAYR DVAWLGECDQ GCLALAELLG WKKELEDLVR REHASIDAQS GAGVPNPSTS ASPKKSPPPA KDEARTTERE KPQ (1-352 aa encoded by BC003547)
靶标信息
The SIRT2 protein (also known as Sirtuin for Silent Mating Type Information 2-Homolog) is a NAD-dependent deacytylase (NDAC) that has been shown to control gene silencing, cell cycle, and DNA damage repair. It is believed that SIRT2 may act as a tumor suppressor in human gliomas and may also serve as a novel molecular marker for these cells. SIRT2 has also been shown to act as a redox sensor to help regulate muscle gene expression in response to food intake and exercise. SIRT2 acts in the phosphorylation cascade involving mitosis where SIRT2 is phosphorylated in late G2 phase, during M phase, and into cytokinesis.
仅用于科研。不用于诊断过程。未经明确授权不得转售。
生物信息学
蛋白别名: 5E5 antigen; mSIR2L2; NAD-dependent deacetylase sirtuin-2; NAD-dependent protein deacetylase sirtuin-2; NAD-dependent protein deacylase sirtuin-2; NAD-dependent protein defatty-acylase sirtuin-2; Regulatory protein SIR2 homolog 2; silent information regulator 2; silent mating type information regulation 2, (S.cerevisiae, homolog)-like; sirtuin 2; SIR2-h; SIR2-like protein 2; sir2-related protein type 2; sir2-related protein type 2; sirtuin type 2; NAD-dependent deacetylase sirtuin-2; silent information regulator 2; SIR2-like protein 2; regulatory protein SIR2; sirtuin type 2; sirtuin-2; unnamed protein product; yeast silent information regulator 2 (Sir2p) homolog
基因别名: 5730427M03Rik; SIR2; SIR2L; SIR2L2; SIRT2
UniProt ID: (Human) Q8IXJ6, (Mouse) Q8VDQ8
Entrez Gene ID: (Human) 22933, (Pig) 100125964, (Mouse) 64383, (Rat) 361532